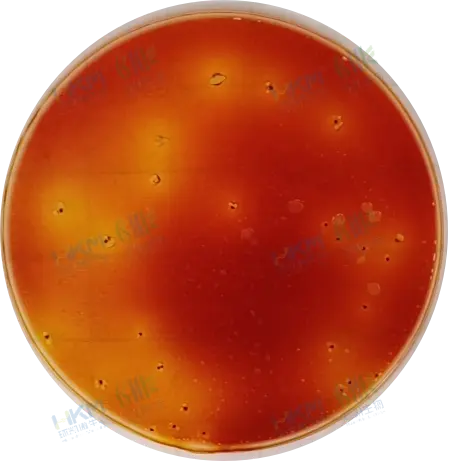
阳性菌,产酸产气特征明显 阳性菌,产酸产气特征明显
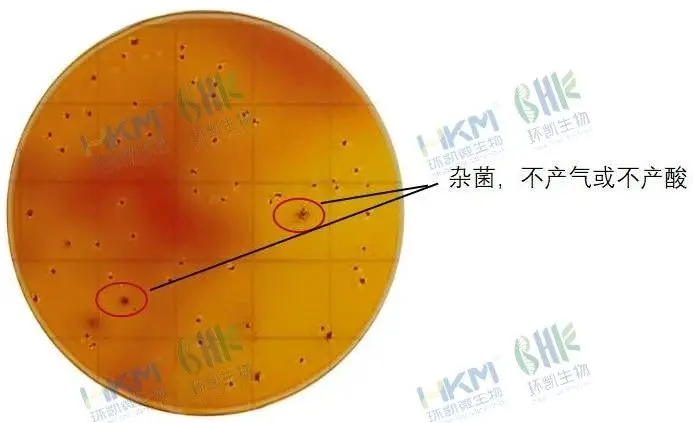
阳性菌与背景菌落区分明显 阳性菌与背景菌落区分明显

新国标发布!环凯生物HandyPlate®大肠菌群测试片助您高效合规检测!
发布时间:2025-04-02 浏览次数:2463 分享:
近日,国家市场监督管理总局正式发布了《GB 4789.3-2025 食品安全国家标准 食品微生物学检验 大肠菌群计数》,该标准将于2025年9月16日正式实施生效。此次更新进一步规范了食品微生物的检测流程,并明确了关键技术要求,为行业的合规性和效率提升提供了重要的指导。
值得注意的是,新标准中引入了大肠菌群计数测试片法,并规定以产酸产气作为阳性结果的判断依据,同时要求此方法的性能需符合《GB 4789.28-食品安全国家标准 食品微生物学检验 培养基和试剂的技术要求》中设定的培养基质量标准。这一变化旨在提高检测的准确性和可靠性,促进食品行业的健康发展,确保食品安全。

环凯生物率先响应新国标!
环凯生物已于2021年成功研发并投产了HandyPlate®大肠菌群测试片。该产品针对饮料、调味品及即食食品等多种类型进行了严格的验证,并与国家标准的传统方法及竞品进行了对比实验,结果表明其性能优异,效果良好,能够有效保障食品微生物检测的准确性和可靠性。

选择 HandyPlate®大肠菌群测试片的理由:
▶ 快速显色:仅需18~24小时即可观察到检测结果,极大地提升了检测效率。
▶ 特征明显:红色菌落周围会出现气泡,并伴有黄色酸环,视觉特征准确地展示了大肠菌群发酵乳糖产酸产气的现象,使得结果判读更加简便直观。
|
| 阳性菌,产酸产气特征明显 |
▶ 选择性强:有效减少杂菌干扰,阳性菌与背景菌落区分明显,确保检测结果更加准确可靠。
▶ 操作简便:无需复杂的试剂配制,采用即开即用的设计,只需将样品直接加至测试片中,然后盖上覆盖膜即可进行培养。
适用场景:适用于食品、饮料、餐饮服务以及环境监测等多个领域进行大肠菌群的快速检测。它帮助企业严格把控质量,确保食品安全,是维护消费者健康的重要工具。
环凯生物致力于微生物监测与控制,为食品药品安全提供坚实保障。我们推出的HandyPlate®大肠菌群测试片,是我们响应最新国家标准、推动检测技术革新的又一力作。
欢迎您体验这一创新技术带来的高效与便捷。欲了解更多信息,请访问环凯微生物官网 / 并搜索“ 大肠菌群测试片 ”。

让我们携手共进,提升食品安全标准!!!





